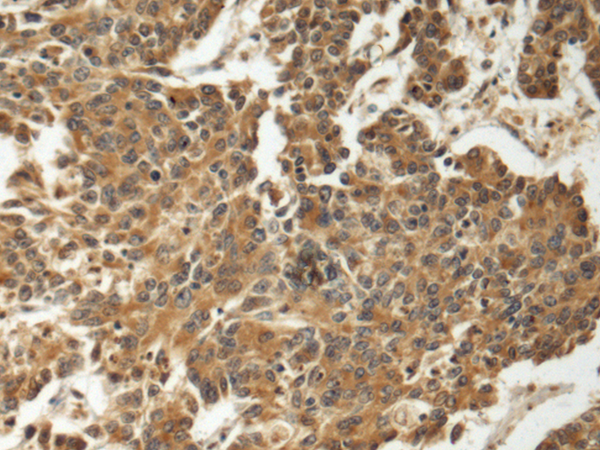
一抗

中文名稱: 兔抗FUK多克隆抗體
技術(shù)規(guī)格
Background:
The protein encoded by this gene belongs to the GHMP (galacto-, homoserine, mevalonate and phosphomevalonate) kinase family and catalyzes the phosphorylation of L-fucose to form beta-L-fucose 1-phosphate. This enzyme catalyzes the first step in the utilization of free L-fucose in glycoprotein and glycolipid synthesis. L-fucose may be important in mediating a number of cell-cell interactions such as blood group antigen recognition, inflammation, and metastatis. While several transcript variants may exist for this gene, the full-length nature of only one has been described to date. [provided by RefSeq, Jul 2008]
Applications:
ELISA, IHC
Name of antibody:
FCSK
Immunogen:
Fusion protein of human FCSK
Full name:
fucose kinase
Synonyms:
FUK; 1110046B12Rik
SwissProt:
Q8N0W3
ELISA Recommended dilution:
5000-10000
IHC positive control:
Human colorectal cancer and Human tonsil
IHC Recommend dilution:
150-300


 購(gòu)物車
購(gòu)物車 幫助
幫助
 021-54845833/15800441009
021-54845833/15800441009